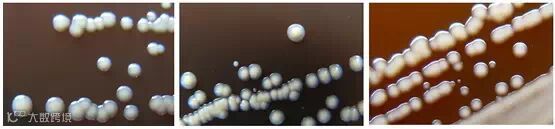

许多人都曾在人生中的某个时候与痤疮不期而遇,并备受其扰。可是科学家对痤疮的病因却知之甚少,疗法上的进展也十分有限。皮肤病学家对付痘痘的武器——过氧化苯甲酰、抗生素和异维A酸——也已经几十年没变过了。这其中,抗生素对大部分严重的痤疮病例都无效,而异维A酸则可能导致严重的副作用。不过,一个今天发表在《皮肤病学研究杂志》(Journal of Investigative Dermatology)上的新发现,却为广大的痤疮患者带来了曙光。
加州大学洛杉矶分校的研究者联合圣路易斯华盛顿大学、洛杉矶生物医学研究所进行了一项研究,发现痤疮杆菌也分正反派,“坏”细菌与致痘有关,而“好”细菌却可能具有保护皮肤的作用。这一发现也许能够启发出大量新的疗法,帮助大家预防和治疗痤疮。
“通过研究我们了解到,并非所有痤疮杆菌都会引发痘痘——其中有一种可能对保持肌肤健康很有帮助,” 这项研究的负责人李慧英向果壳网解释说,她是加州大学洛杉矶分校大卫格芬医学院分子和医学药理学助理教授,同时也是加州大学洛杉矶分校克朗普分子成像研究所的研究员: “我们希望能通过这项发现,找到把痘痘扼杀在萌芽状态的新疗法,也让皮肤病学家能为每一位病人量身设计个性化的抗菌疗法。”
导致痤疮的“魁首”,是一种大名鼎鼎的微生物——痤疮丙酸杆菌(Propionibacterium acnes)。这种细菌每个人的皮肤上都有,靠着毛孔中的油脂茁壮生长,一旦触动了免疫系统,又红又肿的痘痘便鼓会出来。
洛杉矶生物医学研究所和加州大学洛杉矶分校的研究者找来了49个长痘痘的志愿者和52个不长痘痘的志愿者,然后用去黑头鼻贴从他们鼻子上采集细菌。李慧英实验室的研究员从鼻贴上分离出了细菌的 DNA,并通过检测基因标记来鉴别细菌的种类,记录下每个志愿者脸上的细菌种类和皮肤状况。随后,他们将采集到的细菌进行培养,分离出了1000多种细菌。华盛顿大学的研究者对其中属于痤疮丙酸杆菌的66个菌株进行了基因测序。在此基础上,该研究的共同第一作者、加州大学洛杉矶分校的富田秀太(Tomida Shuta)便可以进一步分析每个菌株特有的基因。
论文的其中一位作者、洛杉矶生物医学研究所免疫治疗研究中心的主管、皮肤病学家诺亚•克拉夫特(Noah Craft)评论说,长痘皮肤上分离出的细菌菌种与健康肌肤上的十分不同,长痘痘的志愿者中有20%携有两个独特的痤疮杆菌菌株,但这两个菌株却罕见于不长痘痘的人身上。
“当我们发现另一种常见于健康皮肤却罕见于长痘皮肤的痤疮杆菌时,大家都兴奋极了,” 李慧英说, “我们怀疑这个菌株具有天然的防御机制,即它可以识别出攻击者并在细菌细胞被感染前摧毁攻击者。” 不过,到底是什么因素决定一个人皮肤上痤疮杆菌的种类,目前还不清楚。
从左至右依次是:“坏” 细菌 RT4、RT5;“好” 细菌 RT6。这3种细菌同属于痤疮甲酸杆菌,形态极其相似,可给皮肤带来的影响却截然不同。供图:李慧英
研究者认为,如果可以通过使用一种简单的霜或凝胶来促进 “好” 痤疮杆菌的生长,也许可以缓解长痘的症状。“这种‘好’痤疮杆菌也许能够保护皮肤,就像酸奶中的活菌可以帮人击退胃肠道中的有害细菌一样,”李慧英在接受果壳网采访时表示,“我们下一步要做的是研究这样一种益生菌乳霜能否阻碍有害细菌对皮肤的侵害,预防痘痘的发生。”
另外,还可以进行一些研究,寻找一些可以杀死“坏”细菌同时保护“好”细菌的药物,探索如何利用病毒杀死致痘细菌,设计一个简单的皮肤测试来判断某个个体将来是否会患上严重的痤疮。
圣路易斯华盛顿大学基因组研究所副所长、基因学教授乔治•温斯托克(George Weinstock)评论说:研究了表明在探索人体微生物、确定不同微生物对健康与疾病影响的过程中,菌株(strain)层面的分析十分重要;以前的研究更依赖于细菌培养,或只在不同 “种” (species)的细菌之间加以区分,而这种分析将研究层面从 “种” 细化到 “菌株”,大大提高了研究的精度。
采访的最后,在被问到有没有给自己做一个鼻贴的细菌测试时,李慧英笑说由于自己是研究员所以并没有机会作被试,但她对自己脸上的是 “好” 细菌还是 “坏” 细菌可是 “非常好奇” 呢。
贤集网http://www.xianjichina.com是中国第一家企业技术服务平台!不同学科的技术人员在贤集网这个平台开展合作与交流,让技术打破领域和空间的局限!



